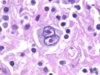

What are some common causes of wheeze in children?
- Viral episodic wheeze - viral infections
- Multiple trigger wheeze - e.g. cold air, dust, exercise - might develop into asthma
- Asthma
Define viral-induced wheeze
An acute illness caused by viral infection.
Small children younger than 3 = small airways, easily inflamed (causing constriction) and develop oedema during viral infection (e.g. RSV)
This swelling and constriction of the airway causes a considerable larger restriction in airflow in a young child compared to an adult or older child
This causes a wheeze, and the ventilatory restriction leads to respiratory distress
Increased risk of developing asthma later in life
How do you differentiate viral-induced wheeze and asthma?
Not definitive, but usually viral-induced wheeze:
- Presenting before 3 years of age
- No atopic history
- Only occurs during viral infections
Asthma can also be triggered by viral or bacterial infections, however it also has other triggers, such as exercise
Asthma is diagnosed based on typical signs and symptoms as well as variable and reversible airflow obstruction.
Presentation and management of viral-induced wheeze
Viral illness for 1-2 days preceding the onset of:
- Shortness of breath
- Signs of respiratory distress
- Expiratory wheeze throughout the chest
TIP: VIW + asthma does not cause focal wheeze, if focal wheeze then senior review and investigation for airway obstruction
Mx: same as acute asthma
Define asthma
Asthma is a chronic inflammatory airway disease leading to variable airway obstruction. The smooth muscle in the airways is hypersensitive and responds to stimuli by constricting and causing airflow obstruction.
Bronchoconstriction is reversible with bronchodilators e.g. salbutamol
Clinical features that indicate likely asthma in a child
- Dry cough with wheeze and shortness of breath
- Diurnal variability, typically worse at night and early morning
- Interval symptoms, i.e. symptoms between acute exacerbations
- Personal /FHx of asthma or other atopic conditions
- Non-viral triggers e.g. dust, exercise, cold air
- Bilateral widespread “polyphonic” (multiple pitch) wheeze heard by a HCP
- Symptoms improve with bronchodilators
How would you describe a wheeze to a parent and child?
A whistling in the chest when your child breaths out and ask if that fits with their child’s symptoms.
Updated 2025 - Investigations to diagnose asthma
Children > 16 + adults:
- Initially FeNO or eosinophil count
- Then reversibility testing with spirometry (>12% increase in FEV1)
- Then peak flow diary twice daily 2w
- Then bronchial challenge test
Children 5 - 16:
- Initially FeNO
- Then reversibility testing with spirometry
- Then peak flow diary twice daily for 2 weeks
- Then skin prick testing to house dust mite or bloods for total IgE and eosinophil count
Children < 5
- Tx til 5, then 8-12w trial of ICS (often VIW rather than asthma)
What questions should you ask if you suspect asthma in a child?
Pattern and phenotype
- How frequent are the symptoms?
- What triggers the symptoms? Specifically, are sports and general activities affected?
- How often is sleep disturbed by asthma?
- How severe are the interval symptoms between exacerbations?
- How much school has been missed due to asthma?
Updated 2025
Medical therapy for asthma in children <5
Stepwise, move up and down the treatment ladder depending on the severity
- Regular low-dose ICS + SABA
- Regular moderate-dose ICS
- Add oral leukotriene receptor antagonist
- Refer to a specialist
Updated 2025
Medical therapy for asthma in children 5 - 11
- SABA (e.g. sabutamol) + Low-dose corticosteroid inhaler (e.g. belcometasone)
- MART (combo ICS and LABA inhaler) or conventional pathway
MART:
1) Low-dose MART
2) Moderate MART
3) Specialist referral
Conventional pathway:
1) add oral leukotriene receptor antgonist (e.g. montelukast)
2) Regular low-dose ICS + LABA combo inhaler
3) Regular moderate-dose ICS + LABA combo inhaler
4) Specialist
Possible exam question:
Discussing inhaled steroids
with a parent who is worried about potential side effects - often about whether they slow growth.
Your answer: Evidence that inhaled steriods can slightly reduce growth velocity and reduce adult height up to 1cm when used long term (>12m). Dose-dependent, smaller dose, less of a problem.
Worth putting into context for the parent that steroids are effective meds to help prevent poorly controlled asthma and asthma attacks - which can lead to higher steroid dose.
Poorly controlled asthma can lead to a more significant impact on growth and development. The child will also have regular asthma reviews to ensure they are growing well and on the minimal dose required to effectively control symptoms.
Asthma: long-term management for children > 12
- AIR therapy
- Low-dose MART
- Moderate-dose MART
- Specialist referral if FeNO or eosinophils are raised at this stage
- Add leukotriene receptor antagonist or LAMA (8-12 week trial and switch if not helping)
- Specialist referral
AIR = ANnti-inflammatory reliever therapy = dry powder inhaler with ICS (e.g. budesonide) + LABA (e.g. formoterol)
Define acute asthma/asthma exacerbations in children
A rapid deterioration in the symptoms of asthma. This could be triggered by any typical asthma triggers, such as viral respiratory infection, exercise or cold weather.
Clinical features of asthma exacerbation
- Progressively worsening SOB
- Signs of respiratory distress - e.g. using accessory muscles to breathe
- Fast respiratory rate (tachypnoea)
- Expiratory wheeze on auscultation
- The chest can sound “tight” on auscultation, with reduced air entry
What is silent chest and why is it a sign of life-threatening asthma?
Where the airways are so tight that the child cannot move enough air through the airways to create a wheeze.
Can be associated with reduced resp effort due to fatigue.
A less experienced clinician might think that the child is not as unwell because there is no wheeze and resp distress, in reality this a silent chest and it is life threatening.
Criteria for moderate asthma (from the BTS/SIGN guidelines 2016)
- Peak flow > 50% predicted
- Able to speak
- O2 sats > 92%
Criteria for severe asthma
- Too breathless to talk
- O2 sats <92%
- Peak flow 33%–50% [best]
Respiratory rate
- > 40 breaths/min < 5 years
- > 30 breaths/min > 5 years
Heart rate
- > 140 beats/min < 5 years
- > 125 beats/min > 5 years
Criteria for life-threatening asthma
Mnemonic 33,92 CHEST. Any one of the following:
- PERF <33%
- O2 <92% or PO2 <8
- Cyanosis
- Hypotension
- Exhaustion, altered consciousness
- Silent chest or poor respiratory effort
- Tachyarrhythmias
Management of asthma exacerbation in children
Moderate exacerbation:
- Inhaled SABA via spacer
- Consider steroids (e.g. oral prednisolone) 3 to 5 days
Severe exacerbation additionally:
- O2 94 to 98%
- Nebulised SABA
- Nebulised ipratropium bromide
If ineffective: - IV mg sulphate
- IV salbutamol
- IV aminophylline
Life-threatening:
- HDU/ICU
- Intubation and ventilation
Bronchodilators used in the management of asthma exacerbation
Stepped up as required
- Inhaled or nebulised salbutamol
- Inhaled or nebulised ipratropium bromide (an anti-muscarinic) alongside with oral or IV steroids if needed
- IV magnesium sulphate
- IV aminophylline
Mmernoic for management of asthma exacerbation
O SHIT ME
O2
Salbutamol
Hydrocortisone (or predinisolone)
Ipratropium
Theophylline
Magnesium sulphate
Escalate care (intubation and ventilation)
Define pneumonia
Infection of the lung tissue. It causes inflammation of the lung tissue and sputum filling the airways and alveoli.
Seen as consolidation on CRX
Caused by bacteria or viruses
Presentation of pneumonia in children
- Cough (productive)
- High fever (> 38.5ºC)
- Tachypnoea
- Tachycardia
- Lethargy
- Delirium (acute confusion associated with infection)